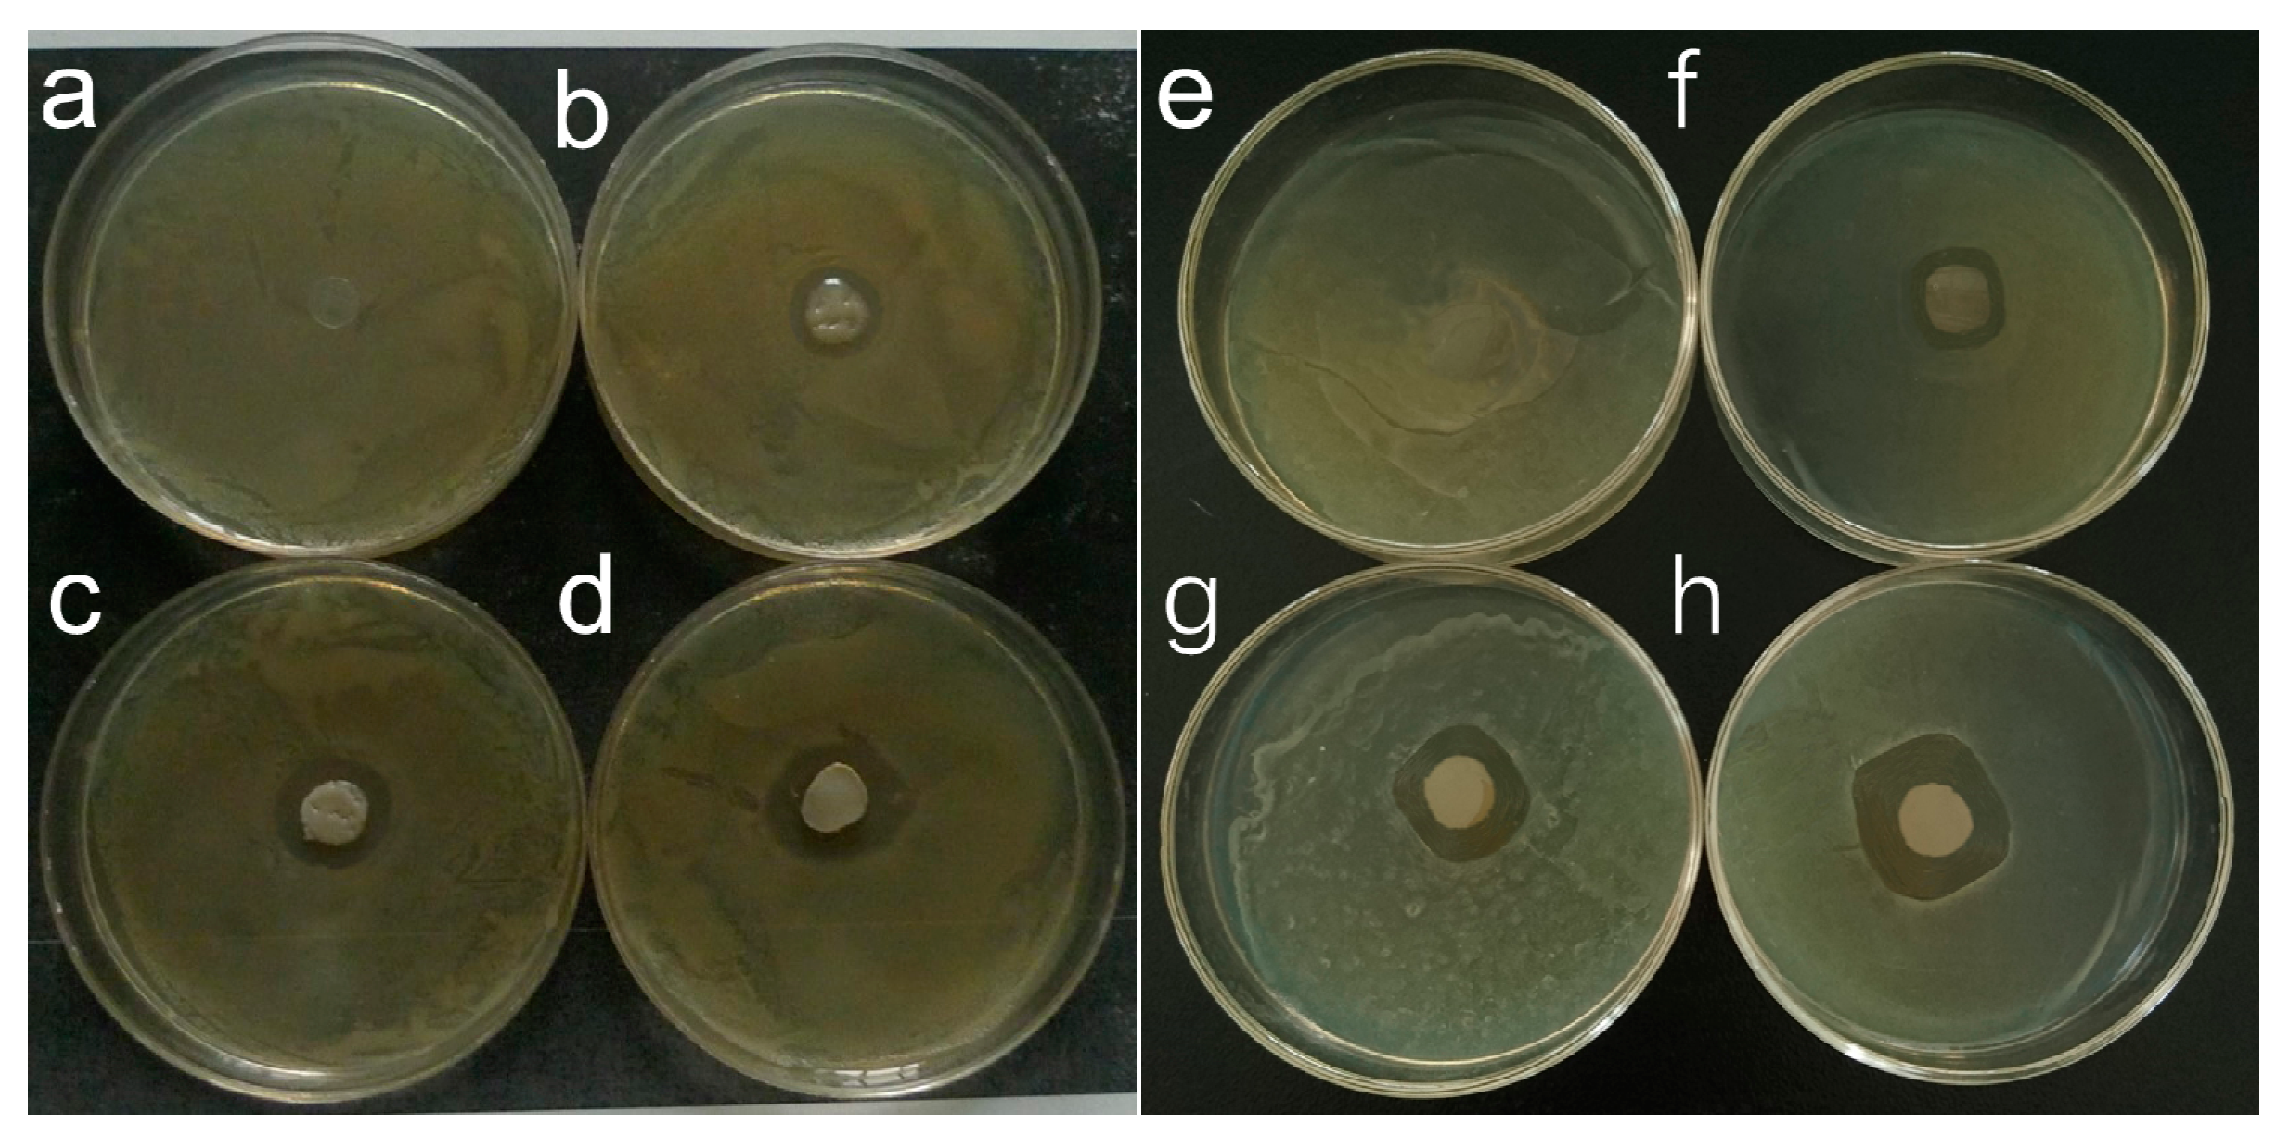
Materials 10 00524 g007

High-Strength Konjac Glucomannan/Silver Nanowires Composite Films with Antibacterial Properties
Abstract
:1. Introduction
2. Materials and Methods
2.1. Materials
2.2. Synthesis of Ag NWs
2.3. Synthesis of Composite Film
2.4. Characterization
2.5. Antimicrobial Tests
3. Results and Discussion
3.1. Basic Information
3.2. X-ray Diffraction (XRD) and Thermal Gravimetric Analysis
3.3. Mechanical Performance
3.4. FT-IR Analysis
3.5. Rheological Analysis
3.6. XPS Analysis
3.7. Antimicrobial Tests
4. Conclusions
Acknowledgments
Author Contributions
Conflict of Interest
References
- Lau, W.J.; Ismail, A.F.; Misdan, N.; Kassim, M.A. A recent progress in thin film composite membrane: A review. Desalination 2012, 287, 190–199. [Google Scholar] [CrossRef]
- Wang, Q.; Wang, J.; Zhong, G. Characteristics of konjac glucomannan (kgm) in a.Bulbifer compared with that in a.Rivieri and a.Albus. Adv. Mater. Res. 2011, 236–238, 2045–2052. [Google Scholar] [CrossRef]
- Mikkonen, K.S.; Tenkanen, M. Sustainable food-packaging materials based on future biorefinery products: Xylans and mannans. Trends Food Sci. Technol. 2012, 28, 90–102. [Google Scholar] [CrossRef]
- Ding, C.C.; Zhang, M.; Li, G.Y. Preparation and characterization of collagen/hydroxypropyl methylcellulose (hpmc) blend film. Carbohydr. Polym. 2015, 119, 194–201. [Google Scholar] [CrossRef] [PubMed]
- Zhang, T.; Xue, Y.; Li, Z.J.; Wang, Y.M.; Xue, C.H. Effects of deacetylation of konjac glucomannan on alaska pollock surimi gels subjected to high-temperature (120 degrees c) treatment. Food Hydrocoll. 2015, 43, 125–131. [Google Scholar] [CrossRef]
- Yu, Z.J.; Jiang, Y.Q.; Zou, W.W.; Duan, J.J.; Xiong, X.P. Preparation and characterization of cellulose and konjac glucomannan blend film from ionic liquid. J. Polym. Sci. Part B Polym. Phys. 2009, 47, 1686–1694. [Google Scholar] [CrossRef]
- Huang, Y.C.; Yang, C.Y.; Chu, H.W.; Wu, W.C.; Tsai, J.S. Effect of alkali on konjac glucomannan film and its application on wound healing. Cellulose 2015, 22, 737–747. [Google Scholar] [CrossRef]
- Xiao, M.; Dai, S.H.; Wang, L.; Ni, X.W.; Yan, W.L.; Fang, Y.P.; Corke, H.; Jiang, F.T. Carboxymethyl modification of konjac glucomannan affects water binding properties. Carbohydr. Polym. 2015, 130, 1–8. [Google Scholar] [CrossRef] [PubMed]
- Duan, J.C.; Lu, Q.; Chen, R.W.; Duan, Y.Q.; Wang, L.F.; Gao, L.; Pan, S.Y. Synthesis of a novel flocculant on the basis of crosslinked konjac glucomannan-graft-polyacrylamide-co-sodium xanthate and its application in removal of Cu2+ ion. Carbohydr. Polym. 2010, 80, 436–441. [Google Scholar] [CrossRef]
- Zhang, H.; Gu, C.H.; Wu, H.; Fan, L.; Li, F.; Yang, F.; Yang, Q. Immobilization of derivatized dextran nanoparticles on konjac glucomannan/chitosan film as a novel wound dressing. Biofactors 2007, 30, 227–240. [Google Scholar] [CrossRef] [PubMed]
- Fernandez, J.G.; Ingber, D.E. Unexpected strength and toughness in chitosan-fibroin laminates inspired by insect cuticle. Adv. Mater. 2012, 24, 480–484. [Google Scholar] [CrossRef] [PubMed]
- Bonderer, L.J.; Studart, A.R.; Gauckler, L.J. Bioinspired design and assembly of platelet reinforced polymer films. Science 2008, 319, 1069–1073. [Google Scholar] [CrossRef] [PubMed]
- Francis, R.; Joy, N.; Aparna, E.P.; Vijayan, R. Polymer grafted inorganic nanoparticles, preparation, properties, and applications: A review. Polym. Rev. 2014, 54, 268–347. [Google Scholar] [CrossRef]
- Hanemann, T.; Szabo, D.V. Polymer-nanoparticle composites: From synthesis to modern applications. Materials 2010, 3, 3468–3517. [Google Scholar] [CrossRef]
- Zhang, F.Y.; Zhou, Y.M.; Cao, Y.; Chen, J. Preparation and characterization of kgm/cds nanocomposite film with low infrared emissivity. Mater. Lett. 2007, 61, 4811–4814. [Google Scholar] [CrossRef]
- Wu, J.H.; Zang, J.F.; Rathmell, A.R.; Zhao, X.H.; Wiley, B.J. Reversible sliding in networks of nanowires. Nano Lett. 2013, 13, 2381–2386. [Google Scholar] [CrossRef] [PubMed]
- Lee, H.; Kim, I.; Kim, M.; Lee, H. Moving beyond flexible to stretchable conductive electrodes using metal nanowires and graphenes. Nanoscale 2016, 8, 1789–1822. [Google Scholar] [CrossRef] [PubMed]
- Wang, J.; Jiu, J.T.; Nogi, M.; Sugahara, T.; Nagao, S.; Koga, H.; He, P.; Suganuma, K. A highly sensitive and flexible pressure sensor with electrodes and elastomeric interlayer containing silver nanowires. Nanoscale 2015, 7, 2926–2932. [Google Scholar] [CrossRef] [PubMed]
- Kwak, W.J.; Jung, H.G.; Lee, S.H.; Park, J.B.; Aurbach, D.; Sun, Y.K. Silver nanowires as catalytic cathodes for stabilizing lithium-oxygen batteries. J. Power Sources 2016, 311, 49–56. [Google Scholar] [CrossRef]
- Lopez-Diaz, D.; Merino, C.; Velazquez, M.M. Modulating the optoelectronic properties of silver nanowires films: Effect of capping agent and deposition technique. Materials 2015, 8, 7622–7633. [Google Scholar] [CrossRef]
- Zeng, X.Y.; Zhang, Q.K.; Yu, R.M.; Lu, C.Z. A new transparent conductor: Silver nanowire film buried at the surface of a transparent polymer. Adv. Mater. 2010, 22, 4484–4488. [Google Scholar] [CrossRef] [PubMed]
- Gaynor, W.; Burkhard, G.F.; McGehee, M.D.; Peumans, P. Smooth nanowire/polymer composite transparent electrodes. Adv. Mater. 2011, 23, 2905–2910. [Google Scholar] [CrossRef] [PubMed]
- Zhao, C.; Deng, B.; Chen, G.C.; Lei, B.; Hua, H.; Peng, H.L.; Yan, Z.M. Large-area chemical vapor deposition-grown monolayer graphene-wrapped silver nanowires for broad-spectrum and robust antimicrobial coating. Nano Res. 2016, 9, 963–973. [Google Scholar] [CrossRef]
- Tang, C.L.; Sun, W.; Lu, J.M.; Yan, W. Role of the anions in the hydrothermally formed silver nanowires and their antibacterial property. J. Colloid Interface Sci. 2014, 416, 86–94. [Google Scholar] [CrossRef] [PubMed]
- Khan, Z.; Hussain, J.I.; Kumar, S.; Hashmi, A.A. Silver nanoplates and nanowires by a simple chemical reduction method. Colloid Surf. B 2011, 86, 87–92. [Google Scholar] [CrossRef] [PubMed]
- Cheng, L.H.; Abd Karim, A.; Seow, C.C. Characterisation of composite films made of konjac glucomannan (kgm), carboxymethyl cellulose (cmc) and lipid. Food Chem. 2008, 107, 411–418. [Google Scholar] [CrossRef]
- Alsharaeh, E.H. Polystyrene-poly(methyl methacrylate) silver nanocomposites: Significant modification of the thermal and electrical properties by microwave irradiation. Materials 2016, 9, 458. [Google Scholar] [CrossRef]
- Yu, H.Q.; Huang, Y.H.; Ying, H.; Xiao, C.B. Preparation and characterization of a quaternary ammonium derivative of konjac glucomannan. Carbohydr. Polym. 2007, 69, 29–40. [Google Scholar] [CrossRef]
- Tamboli, M.S.; Kulkarni, M.V.; Patil, R.H.; Gade, W.N.; Navale, S.C.; Kale, B.B. Nanowires of silver-polyaniline nanocomposite synthesized via in situ polymerization and its novel functionality as an antibacterial agent. Colloids Surf. B Biointerfaces 2012, 92, 35–41. [Google Scholar] [CrossRef] [PubMed]
- Shahzadi, K.; Wu, L.; Ge, X.S.; Zhao, F.H.; Li, H.; Pang, S.P.; Jiang, Y.J.; Guan, J.; Mu, X.D. Preparation and characterization of bio-based hybrid film containing chitosan and silver nanowires. Carbohydr. Polym. 2016, 137, 732–738. [Google Scholar] [CrossRef] [PubMed]
- Yang, C.; Gu, H.; Lin, W.; Yuen, M.M.; Wong, C.P.; Xiong, M.; Gao, B. Silver nanowires: From scalable synthesis to recyclable foldable electronics. Adv. Mater. 2011, 23, 3052–3056. [Google Scholar] [CrossRef] [PubMed]
- Huang, L.; Takahashi, R.; Kobayashi, S.; Kawase, T.; Nishinari, K. Gelation behavior of native and acetylated konjac glucomannan. Biomacromolecules 2002, 3, 1296–1303. [Google Scholar] [CrossRef] [PubMed]
- Zhang, H.; Yoshimura, M.; Nishinari, K.; Williams, M.A.; Foster, T.J.; Norton, I.T. Gelation behaviour of konjac glucomannan with different molecular weights. Biopolymers 2001, 59, 38–50. [Google Scholar] [CrossRef]
- Tian, D.; Hu, W.; Zheng, Z.; Liu, H.; Xie, H.-Q. Study on in situ synthesis of konjac glucomannan/silver nanocomposites via photochemical reduction. J. Appl. Polym. Sci. 2006, 100, 1323–1327. [Google Scholar] [CrossRef]
- Du, X.Z.; Yang, L.X.; Ye, X.; Li, B. Antibacterial activity of konjac glucomannan/chitosan blend films and their irradiation-modified counterparts. Carbohydr. Polym. 2013, 92, 1302–1307. [Google Scholar] [CrossRef] [PubMed]
- Fan, L.; Zhu, H.; Zheng, H.; Xu, Y.; Zhang, C. Structure and properties of blend fibers prepared from alginate and konjac glucomannan. J. Appl. Polym. Sci. 2007, 106, 3903–3907. [Google Scholar] [CrossRef]

| Samples | Thickness (mm) | Transparency (%) | WVP × 1014 (Kg Pa−1 s−1 m−1) | Water Content (%) |
|---|---|---|---|---|
| KGM | 0.16 ± 0.01 | 85 ± 0.8 | 1.36 ± 0.19 | 0.21 ± 0.06 |
| KGM-Ag NWs-1% | 0.17 ± 0.02 | 43 ± 0.5 | 1.16 ± 0.25 | 0.19 ± 0.07 |
| KGM-Ag NWs-2.5% | 0.19 ± 0.02 | 20 ± 0.6 | 0.8 ± 0.17 | 0.18 ± 0.05 |
| KGM-Ag NWs-5% | 0.20 ± 0.03 | 3 ± 0.2 | 0.3 ± 0.04 | 0.16 ± 0.03 |
© 2017 by the authors. Licensee MDPI, Basel, Switzerland. This article is an open access article distributed under the terms and conditions of the Creative Commons Attribution (CC BY) license (http://creativecommons.org/licenses/by/4.0/).
Share and Cite
Lei, J.; Zhou, L.; Tang, Y.; Luo, Y.; Duan, T.; Zhu, W. High-Strength Konjac Glucomannan/Silver Nanowires Composite Films with Antibacterial Properties. Materials 2017, 10, 524. https://doi.org/10.3390/ma10050524
Lei J, Zhou L, Tang Y, Luo Y, Duan T, Zhu W. High-Strength Konjac Glucomannan/Silver Nanowires Composite Films with Antibacterial Properties. Materials. 2017; 10(5):524. https://doi.org/10.3390/ma10050524
Chicago/Turabian StyleLei, Jia, Lei Zhou, Yongjian Tang, Yong Luo, Tao Duan, and Wenkun Zhu. 2017. "High-Strength Konjac Glucomannan/Silver Nanowires Composite Films with Antibacterial Properties" Materials 10, no. 5: 524. https://doi.org/10.3390/ma10050524





